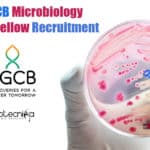
Govt RGCB Microbiology Research Fellow Recruitment RGCB Microbiology Research Fellow
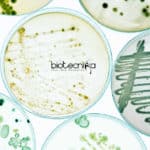
U.S. Pharmacopeial Convention Scientist – Microbiology US Pharmacopeial Convention Jobs

Home Search
biology - search results
If you're not happy with the results, please do another search
Cepheid Molecular Biology Scientist Job Vacancy Available
Cepheid Molecular Biology Scientist Job Vacancy Available
Cepheid Molecular Biology Scientist Job Vacancy Available. Indian nationals can apply for a Field Application Specialist job at...
NRCB JRF & Project Fellow Jobs For Biotech & Molecular Biology
NRCB JRF & Project Fellow Jobs For Biotech & Molecular Biology
NRCB JRF & Project Fellow Jobs For Biotech & Molecular Biology. Biotechnology & Molecular...
NIMHANS Stem Cell Biology & Life Science Project Recruitment
NIMHANS Stem Cell Project Job For Life Sciences - JRF Opening
NIMHANS Stem Cell Project Job For Life Sciences - JRF Opening. MSc Stem Cell...
ICAR-NBAIR Molecular Biology & Bioinformatics SRF Recruitment
ICAR-NBAIR SRF Job For Bioinformatics & Molecular Biology
ICAR-NBAIR SRF Job For Bioinformatics & Molecular Biology. Senior Research Fellow post for msc bioinformatics and molecular...
Govt RGCB Project Assistant Job For Microbiology / Zoology / Biotech
RGCB Project Job For Microbiology / Zoology / Biotech
RGCB Project Job For Microbiology / Zoology / Biotech. RGCB, Thiruvananthapuram is hiring MSc candidates. Microbiology/Zoology/...
NITRD Biotech & Microbiology Research Job With Rs. 47,000 pm Salary
NITRD Research Vacancy For Microbiology & Biotechnology
NITRD Research Vacancy For Microbiology & Biotechnology. National Institute of Tuberculosis and Respiratory Diseases jobs for MSc Microbiology/Biotechnology...
IIT Jodhpur Biology Project Assistant Job Openings – Apply Online
IIT Jodhpur Biology Project Assistant Job Openings - Apply Online
IIT Jodhpur Biology Project Assistant Job Openings - Apply Online. MSc Junior Research Fellow vacancy...
ICAR-CIPHET Microbiology Research Vacancies – Applications Invited
ICAR-CIPHET Microbiology Research Vacancies - Applications Invited
ICAR-CIPHET Microbiology Research Vacancies - Applications Invited. Microbiology Job Openings. Junior Research Fellow & Project Associate Job Vacancies....
IISER TVM Biology Junior Research Fellow Job Opening
IISER TVM Biology Junior Research Fellow Job Opening
IISER TVM Biology Junior Research Fellow Job Opening. IISER TVM is hiring Biology candidates for Junior Research...
IISER Mohali Microbiology Research Fellow Job Opening
IISER Mohali Microbiology Research Fellow Job Opening
IISER Mohali Microbiology Research Fellow Job Opening. Junior Research Fellow Job for microbiology candidates. MSc jobs. IISER Mohali...
Govt RGCB Microbiology Research Fellow Recruitment
RGCB Microbiology Research Fellow Recruitment 2021
RGCB Microbiology Research Fellow Recruitment 2021. RGCB, Thiruvananthapuram is hiring MSc candidates. Microbiology Junior Research Fellow Job Opening. Interested...
U.S. Pharmacopeial Convention Scientist – Microbiology
US Pharmacopeial Convention Jobs - Scientist, Microbiology
US Pharmacopeial Convention Jobs - Scientist, Microbiology. MSc Biotech, Biochem & Microbiology can apply. Interested and eligible applicants...
IISER Pune Life Science & Biology Research Fellow Recruitment
IISER Pune Vacancy SRF - Life Science & Biology Apply
IISER Pune Vacancy SRF - Life Science & Biology Apply. IISER Pune is hiring Life...
CSIR-CIMAP Associate Recruitment – Biotech / Biochem & Microbiology Apply
CIMAP Jobs Latest - Biotech / Biochem & Microbiology Apply
CIMAP Jobs Latest - Biotech / Biochem & Microbiology Apply. Government jobs for MSc in...
Unilever Microbiology & Virology R&D Associate Recruitment
Unilever R&D Associate Jobs - Microbiology & Virology Apply
Unilever R&D Associate Jobs - Microbiology & Virology Apply. MSc Microbiology/ Virology candidates are encouraged to...